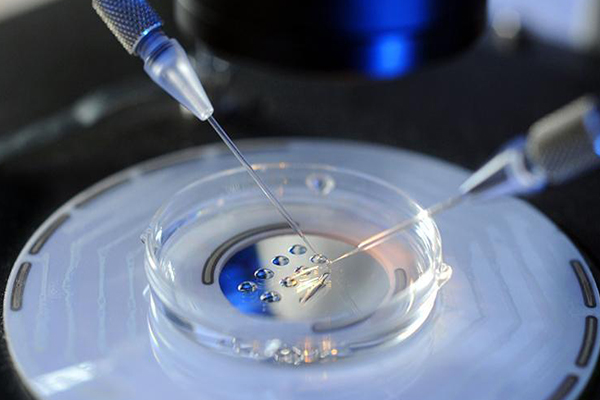
a59c31c30419a502a82c12d41510074c.jpg 国内冻卵费用大约多少

现在很多年轻人不愿意过早生育,但很多人担心身体老化后,想生孩子的时候生不了,于是把目光放在了冻卵上。做了冻卵的女性可以等想生育的时候将卵子解冻并进行试管婴儿,以防以后生不了孩子。那么,国内冻卵费用大约多少?国内冻卵费用受什么因素影响?
国内冻卵费用大约多少
一般来说,冻卵的成本包括两部分:取卵操作+保存成本。通常,卵子冷冻费用在3000-4000元。支付这笔费用后,卵子可以为患者保存3个月。那么如果还需要继续冻卵,每个月需要交150元。
目前国内第一次做冻卵的保存费用约为15000-30000元,之后卵子保存费用每年需要1200-1800元。根据不同的机构,冻卵的收费是不一样的。冻卵的收费不是根据冻卵的数量来定的,而是只根据冻卵的批次来定的,即一批冻卵收费一次。

国内冻卵费用受什么因素影响
除了上述不同机构、不同国家和地区会影响卵子冷冻成本外,年龄和AMH也会影响卵子冷冻成本。
1、年龄:年龄对卵子的数量和质量起着重要的作用。例如,冻卵时间越晚,在取卵操作中可能获得的活卵越少,更多轮次的取卵操作将增加成本。在冻卵中,高龄女性可能需要比年轻女性多次促排卵来获得更多的卵子,以获得相同的冻卵功能。
2、AMH值:AMH值越低,卵巢储备功能越差。同样,一次获得的卵子数量越少,卵子冷冻的成本就越高。
目前国内冻卵技术并不成熟,只有少数医院开展了该项目。况且冻卵需要严格的医学指征,不是所有人都能做的。申请冻卵的女性必须持有结婚证、出生证和身份证,否则医院不会受理申请。
